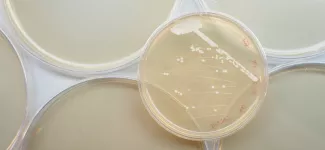
yeast

Source: UBC News
Why do people respond differently to the same drug? For the first time, researchers have untangled genetic and environmental factors related to drug reactions, bringing us a step closer to predicting how a drug will affect us.
Researchers at the University of British Columbia exposed 6,000 strains of yeast to 3,000 drugs. Yeast strains were modified so their response could be measured. Researchers found that the yeast cells have about 50 main ways in which they react to any drug.
These 50 major response types, known as gene signatures, are like fingerprints that identify all genes and their relevance to a specific drug treatment.
This relatively small number of gene signatures means that it might be possible to eventually use a person's genome to predict their drug response. It could also make it easier to identify more effective therapies.
"This is a starting reference map for understanding variation in drug response," says Guri Giaever, an associate professor in UBC's Faculty of Pharmaceutical Sciences, and a senior author on the study, published today in Science. "It won't be easy but our results suggest it is a solvable problem."
Corey Nislow, also associate professor in the faculty and senior author, says this research will help us better understand how and why some drugs work and others don't.
The findings may also be relevant to cancer treatment. Researchers identified all genes that are essential for growth when cells are chemically stressed. Because cancer is principally a cell that grows out of control, the research points to different strategies to develop new drugs that target these genes.
Image: Martin Dee.